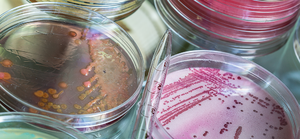

Очаговый туберкулез легких характеризуется ограниченным преимущественно продуктивным воспалительным процессом и хроническим малосимптомным клиническим течением. При этой форме туберкулеза имеется прямая зависимость между характером морфологической реакции и клиническим течением болезни
До последнего времени очаговый туберкулез легких считался самым частым проявлением легочного туберкулеза взрослых. И в настоящее время на многих территориях нашей страны очаговый туберкулез легких составляет 40—50% среди всех впервые выявленных больных. Особенно много больных очаговым туберкулезом легких выявляется на тех территориях, где проводится массовая сплошная флюорография населения в возрасте 12—14 лет и старше. До недавнего времени считалось, что наличие большого числа больных очаговым туберкулезом легких — благоприятный показатель выявления туберкулеза и свидетельство хорошей организации выявления. Но последние данные свидетельствуют о том, что там, где флюорография проводится уже несколько лет, удельный вес очагового туберкулеза легких с 40-50% снижается до 30% и возрастает удельный вес другой клинической формы туберкулеза — инфильтративныи туберкулез. Это объясняется более полной осведомленностью противотуберкулезных диспансеров о всех лицах с изменениями туберкулезного характера в легких и развитием инфильтратив-ного туберкулеза у лиц без видимых рентгенологических изменений в легких в период между флюорографическими исследованиями.
Мрфологические изменения, характерные для очагового туберкулеза легких, были описаны еще в начале текущего столетия А. И. Абрикосовым, который считал, что у взрослого инфицированного туберкулезом человека очаговый туберкулез возникает вследствие экзогенной суперинфекции.
А. И. Абрикосов, характеризуя очаги в верхушках, которые получили em имя, отмечал, что, кроме поражения паренхимы легкого поражаются и концевые отделы бронхиальной системы, т. е. очаг начинается прежде всего с эндобронхита. В последующем об этом писал и крупный русскии фтизиатр А. Н. Рубель Эти авторы полагали, что поражение бронхов и бронхиол воз никает вследствие экзогенной суперинфекции, после чего появляется и очаг пневмонии с быстрым переходом воспалительной реакции из экссудативной в продуктивную. Г. Р. Рубинштейн (1949) также считал, что очаговый туберкулез развивается в связи с суперинфекцией.
Однако были и другие представления о патогенезе очагового туберкулеза. Б. М. Хмельницкий и М. Г. Иванова (1959) считали, что очаговый туберкулез легких развивается, как правило, в результате эндогенной реактивации старых очагов.
В настоящее время принято считать, что хотя экзогенный механизм возникновения очагового туберкулеза возможен, такой генез очагового процесса в современных условиях встречается сравнительно редко. Чаще очаговый туберкулез возникает не в результате суперинфекции, а вследствие реактивации старых остаточных изменений туберкулезной инфекции в организме человека.
Наиболее частым источником очагового туберкулеза легких являются остаточные очаги, образовавшиеся в период первичной туберкулезной инфекции; как правило, они локализуются в верхушках легких, иногда видны на рентгенограммах в виде мелких кальцинатов.
В течение длительного времени не удавалось раскрыть механизм развития очагового туберкулеза вследствие эндогенной реактивации старых остаточных изменений, хотя имелись четкие данные морфологических исследований, доказывающих взаимосвязь между обострившимися старыми и новыми свежими очагами. Данные бактериологических исследований резецированных участков легких по поводу туберкулеза и нетуберкулезных заболеваний свидетельствовали о том, что из старых туберкулезных очагов, в том числе верхушечных, высеять микобактерии туберкулеза, как правило, не удавалось.
Каким образом микобактерии, которые не растут даже на питательных средах, вызывают реактивацию очагов? Этот вопрос длительное время не имел ответа. В работах, вышедших из Центрального института туберкулеза, Н. А. Шмелев, 3. С. Земскова, И. Р. Дорожкова (1973) показали, что в старых очагах могут сохраняться так называемые персистирующие формы микобактерий туберкулеза, несмотря на отсутствие признаков активности туберкулеза. Нередко одной из форм персистирова-ния является L-трансформация микобактерий. При соответствующих условиях и при благоприятной ситуации происходит их реверсия, т. е. превращение персистирующих в старых очагах микобактерий в обычные жизнеспособные, размножающиеся микобактерии, которые и вызывают вспышку туберкулеза. В настоящее время реактивация старых очагов и развитие очагового туберкулеза нередко наблюдаются у лиц пожилого возраста, у которых период между возникновением очагового туберкулеза и первичным заражением изменяется десятками лет.
Очаговый туберкулез легких может возникать также при хроническом первичном туберкулезе легких. Сейчас таких больных мало, но если у них длительное время сохраняется активный процесс в лимфатических узлах средостения, на том или ином этапе жизни возникает очаговый процесс. Если имеет место гематогенная диссеминация, то очаги возникают в верхушках; если возникает лимфобронхогенное обсеменение, то очаги появляются в средних и нижних отделах легких. Особенно часто в средних и нижних отделах легких очаги возникают при наличии бронхоаденита и эндобронхита, если наряду с хроническим воспалительным процессом в лимфатических узлах средостения имеется туберкулез крупных бронхов или трахеи.
Очаговый туберкулез легких в виде исключения может возникать в результате гематогенной диссеминации из экстрапуль-мональных активных туберкулезных очагов. Но чаще всего, как правило у взрослых, очаговый процесс развивается в результате обострения верхушечных очагов, поэтому чаще очаговый туберкулез у взрослых локализуется в верхушках легких.
Следует также подчеркнуть, что не всегда очаговый туберкулез является началом легочного процесса, он может быть исходом других клинических форм легочного туберкулеза. В настоящее время, когда имеется возможность излечивать подавляющее большинство впервые выявленных больных, такой генез очагового туберкулеза легких встречается нередко. У таких лиц очаговые изменения — не начало туберкулезного процесса, а результат инволюции, заживления инфильтративного, кавернозного диссеминированного туберкулеза легких. Практически любая форма легочного туберкулеза при процессах заживления, инволюции может трансформироваться в очаговые изме-нения
Если этот процесс заживления продолжается дальше и постепенно теряются признаки активности очаговых изменении, со временем сохраняющиеся фиброзно-очаговые изменения трактуются как остаточные изменения после излеченного туоеркулеза.
Конечно, необязательно, чтобы в результате излечения очагового туберкулеза образовывались фиброзно-очаговые изменения очаги могут рассасываться, на их месте могут образовываться незначительные рубцовые изменения. Очаговый процесс может прогрессировать, в этих случаях очаговый туберкулез легких может дать начало и деструктивным изменениям.
В 50-х годах распад находили у 11-14% всех выявленньх больных очаговым туберкулезом, фаза распада выявляется у 4-8% больных очаговым туберкулезом. По-видимому, в настоящее время больные очаговым туберкулезом легких подвергаются^более тщательному обследованию, в том числе с целью определения активности туберкулеза и лечения.
Очаговый туберкулез легких может протекать длительно незаметно для больного; такие больные могут быть выявлены спустя много лет после начала заболевания, когда о нем уже нельзя говорить как о ранней форме. Поэтому последнее время очаговый туберкулез легких стали относить к разряду не ранних, а малых форм туберкулеза. Малые формы туберкулеза — это те проявления болезни, которые характеризуются ограниченным воспалительным туберкулезным процессом и редким: развитием распада.
Очаговый туберкулез легких характеризуется, как правило, длительным хроническим волнообразным течением со сменой фаз обострения и затихания, но даже в период вспышки характерно отсутствие ярких клинических проявлений. Это значит, что больные могут не знать о своей болезни; естественно, такие люди за медицинской помощью не обращаются и остаются неизвестными ни фтизиатрам, ни терапевтам. Поэтому при отсутствии сплошного флюорографического обследования населения многие больные очаговым туберкулезом легких остаются неизвестными диспансеру. Однако с началом сплошного флюорографического обследования населения выявляется большое число лиц с очагами в легких — на разных этапах туберкулезного процесса, на разных фазах очагового процесса, с наличием вспышки и в фазе интервала, без проявлений эффективности туберкулезного процесса. Это обстоятельство затрудняет определение активности очагового туберкулеза.
Чаще всего порядок обследования больного следующий: собрать анамнез, изучить жалобы больного, применить свето-акустические методы, а потом — рентгенологическое исследование. Если таким образом обследовать больного очаговым туберкулезом, неизвестно, в каком месте надо искать хрипы, изменение дыхания и в каком случае нужно просить больного покашлять для выявления хрипов. Поэтому сейчас мы рекомендуем после рентгенологического исследования провести физическое исследование, включая перкуссию, аускультацию. Если при рентгенологическом исследовании выявляются очаги, необходима целенаправленная аускультация — именно в том месте, где располагаются очаги, где имеется воспалительная реакция.
При стетоакустическом исследовании у больных в период обострения иногда можно выслушать хрипы, правда, лишь на ограниченном участке после покашливания. Если больной не лечился, иногда даже без распада можно выслушивать хрипы, но чаще влажные хрипы выслушиваются у больных при появлении деструкции легкого. Нужно к этому добавить, что, хрипы выслушиваются короткое время, иногда несколько дней; если больной в это время не попадает к врачу, то потом уже хрипы прослушать не удается, они исчезают очень быстро, поэтому целенаправленная аускультация должна проводиться после рентгенологического исследования. Если при рентгенологическом исследовании обнаружены очаги, не следует спешить с началом химиотерапии. Нужно дообследовать больного полностью, тем более что при очаговом туберкулезе процесс не течет бурно, не характеризуется быстрым прогрессирующим течением. Это вялый, медленно развивающийся процесс, и если 2—3 дня больного не лечить, опасности это не представляет, зато можно получить ценные данные, говорящие об активности процесса.
Наиболее информативным методом в диагностике очагового туберкулеза является рентгенологическое исследование (рис 33*) без которого невозможно поставить диагноз очагового туберкулеза легких, нельзя определить локализацию очагов их число, плотность и характер контуров. Свежии очаговый туберкулез характеризуется мягкими очаговыми тенями. При большей продолжительности заболевания очаги — средней плотности и полиморфные. Кроме рентгенолгического метода, большое значение в диагностике очагового туберкулеза имеет обнаружение микобактерий в мокроте. При ее отсутствии следует прибегать к провоцирующим кашель ингаляциям раствора поваренной соли с последующим изучением мокроты или исследованию промывных вод бронхов iМикроскопическому исследованию необходимо подвергать не^ менее 3 ежедневно собранных порций мокроты и 2—3-кратныи посев материала на питательные среды.
У больных очаговым туберкулезом в фазе инфильтрации микобактерии туберкулеза обнаруживаются даже при тщательном микроскопическом исследовании у 3% больных. Если применить метод посева, то частота выявления микобактерий у больных активным туберкулезом легких в фазе инфильтрации без распада, по данным В. П. Шаенко (1970) достигает 30% по данным Н. М. Рудого (1975) — 50%. Как правило, у больных очаговым туберкулезом бактериовыделение скудное, но имеет большое диагностическое значение для подтверждения диагноза туберкулеза; кроме того, наличие микобактерий является надежным подтверждением активности туберкулеза. Если при рентгенологическом исследовании выявляются плотные очаги, бактериолгический метод малорезультативен и тогда применяют другие методы определения активности (подкожное введение туберкулина в сочетании с лабораторными исследованиями). Лица, у которых трудно определить активность туберкулезного процесса, включаются в нулевую группу диспансерного учета. Основную массу пациентов, наблюдаемых по нулевой группе учета, составляют лица с очаговым туберкулезом легких в фазе уплотнения.
Если указанные методы не помогают установить активность туберкулезного процесса, приходится прибегать к так называемому тест-лечению. Таким больным в течение 2—3 мес назначают химиотерапию и изучают рентгенологическую динамику с учетом субъективного состояния больного, картину крови в динамике и т. д. При очаговом туберкулезе лейкограмма может изменяться, повышается СОЭ, но этот метод не очень надежен. Такие сдвиги могут быть обусловлены интеркуррентными заболеваниями, поэтому очень трудно трактовать эти изменения как проявление туберкулеза. Следует исключить все интеркуррентные заболевания, тогда все изменения в лейкограмме могут быть использованы как показатель интоксикации, и если в процессе химиотерапии они нормализуются, это подтверждает предположение об активности туберкулезных очагов. Поэтому наиболее надежным критерием активности является динамика рентгенологической картины — рассасывание (полное или частичное) очагов.
Активность очагового туберкулеза может быть определена также с помощью бронхоскопии, если обнаруживается свежий эндобронхит.
Выделяют два варианта в течении очагового туберкулеза. К очаговым формам относятся:
1) как недавно возникшие, свежие так называемые мягкоочаговые процессы размером очагов до 10 мм;
2) так и более давние, старые фиброзноочаговые образования, но с признаками активности процесса.
1. Свежий очаговый туберкулез характеризуется наличием мелких зон инфильтрации до 10 мм в виде слабоконтурирующихся мягких очаговых теней со слегка размытыми краями.
2. Фиброзноочаговый туберкулез проявляется наличием более плотных и интенсивных очагов, иногда с включением извести, фиброзными изменениями вокруг в виде тяжей и участков гиперпневматоза. При фиброзноочаговом туберкулеза в период обострения, наряду со старыми могут также появляться и свежие, мягкие очаги, т.е. обнаруживаться очаги различной плотности и интенсивности, что свидетельствует об их потенциальной активности.
Надо отметить, что независимо от варианта течения, морфологические изменения при очаговом туберкулезе легких характеризуются, как правило, преимущественно продуктивной воспалительной реакцией небольшой протяженности с казеозом в центре.
Оформление диагноза согласно клинической классификации:
Очаговый туберкулез (мягкоочаговый) в S1 правого легкого в фазе инфильтрации (и распада), БК- (минус).
Распространенность и удельный вес. До последнего времени очаговый туберкулез легких считался самым частым проявлением легочного туберкулеза у взрослых. И до настоящего времени на некоторых территориях бывшего СССР он составляет в структуре заболеваний до 30-40% среди всех впервые выявленных больных. Однако там, где флюорография как метод массовой общедоступной диагностики применяется регулярно уже несколько лет подряд, удельный вес очагового туберкулеза снижается до 20-25% и возрастает удельный вес другой клинической формы – инфильтративного туберкулеза, что имеет место в настоящее время и в Республике Беларусь.
Источники инфекции и патогенез развития. Известный патологоанатом А.И. Абрикосов, характеризуя очаги в верхушках легких, (которые в последующем получили его имя), отмечал, что туберкулезный очаг начинается, прежде всего с эндобронхита, как следствие экзогенной суперинфекции. После чего появляется небольшой очаг пневмонии в легком с быстрым переходом экссудативной воспалительной реакции в продуктивную.
1. Подобную теорию поддерживали крупные русские фтизиатры того времени А.Н. Рубель и Г.Р. Рубинштейн. Они считали, что очаговый туберкулез всегда возникает в связи с суперинфекцией.
2. Представители украинской школы Б.М. Хмельницкий и М.Г. Иванова придерживались другого представления о патогенезе очагового туберкулеза и утверждали, что очаговый туберкулез развивается, как правило, в результате эндогенной реактивации старых очагов.
В настоящее время не только в странах СНГ, но за рубежом принято считать, что экзогенный механизм очагового туберкулеза, хотя и возможен, но в современных условиях встречается значительно реже.
Чаще всего очаговый туберкулез возникает не в результате суперинфекции, а вследствие реактивации старых остаточных изменений туберкулезной инфекции в организме человека как первичного, так и вторичного периодов.
В последние годы работами отечественных фтизиатров Н.А. Шмелева, З.С. Земсковой, И.Р. Дорожковой показано, что в старых очагах могут сохраняться не патогенные, а так называемые персистирующие формы микобактерий туберкулеза, несмотря на отсутствие признаков активности туберкулеза (происходит L–трансформация БК).
При соответствующих условиях и при благоприятной ситуации происходит их реверсия, т.е. превращение персистирующих микобактерий в обычные, жизнеспособные, размножающиеся микобактерии, которые могут вызвать вспышку туберкулеза в виде ограниченного очагового процесса.
Вторым источником очагового туберкулеза легких может явиться хронически текущий первичный туберкулез легких. Сейчас таких больных, правда, мало, но все-таки они встречаются. Если длительное время сохраняется активный туберкулезный процесс в лимфатических узлах средостения, у таких больных на том или ином этапе может возникнуть очаговый процесс вторичного периода лимфогенного генеза.
В виде исключения, третьим источником очаговых измененийв легких может явиться гематогенная диссеминация из экстрапульмональных (внелегочных) активных туберкулезных очагов различной локализации.
И, наконец, при четвертом источнике очаговый туберкулез легких может быть исходом, обратным развитием других клинических форм легочного туберкулеза. Такой генез в связи с успехами химиотерапии в настоящее время встречается не так уж редко.
У таких лиц формирующиеся очаговые изменения надо рассматривать не как начало туберкулезного процесса, а как результат инволюции, обратного развития, результат заживления инфильтративного, кавернозного, диссеминированного туберкулеза легких. При этом формируется всегда фиброзно-очаговый туберкулез. В подобных случаях диагноз очагового туберкулеза ставится на каком-то этапе процесса заживления.
Чаще очаговый туберкулез легких характеризуется малосимптомным клиническим течением, хотя нередко наблюдается инаперцептное течение, т.е. с минимальными клиническими признаками туберкулезной интоксикации, которым больной в начале заболевания не придает существенного значения. Острого начала, как правило, не бывает или отмечается в виде исключения.
Все клинические проявления очагового туберкулеза можно разделить на две группы:
1) синдром общей маловыраженной интоксикации;
1. Синдром общей интоксикации:
1) субфебрильная (реже кратковременная фебрильная) температура тела – чаще во второй половине дня;
2) повышенная потливость (чаще в ночное время);
3) понижение работоспособности;
4) вялость, усталость;
5) появление синдрома невыраженной, длительной, иногда волнообразной вегето-сосудистой дистонии;
6) нарушение сна и аппетита.
2. Грудные симптомы:
1) небольшой или невыраженный кашель (покашливание) с незначительным количеством мокроты или без мокроты;
2) иногда невыраженные мелкопузырчатые влажные хрипы на высоте вдоха или при покашливании хрипы определяемые на ограниченном участке одной из верхушек легких;
3) бронхиальный оттенок дыхания;
4) иногда укорочение перкуторного звука;
5) очень редко кровохарканье как яркий симптом, привлекающий внимание врача и больного.
В целом клиника очагового туберкулеза легких характеризуется скудностью и невыраженностью симптоматики, вплоть до ее отсутствия. Общий вид больных, как правило, не страдает.
Очаговый туберкулез легких при позднем выявлении и отсутствии лечения характеризуется обычно длительным хроническим волнообразным течением со сменой фаз невыраженного обострения и затихания, но даже в период вспышки характерно отсутствие ярких клинических проявлений.
Следует отметить, что симптомы интоксикации чаще отмечаются при мягкоочаговом варианте очагового туберкулеза легких, чем при фиброзноочаговом в виду того что при последнем происходит адаптация организма к существующему длительно туберкулезному процессу.
Особое внимание следует обратить, что наиболее информативным методом в диагностике очагового туберкулеза является плановые, регулярные рентгенофлюорографические исследования или выполняемые по показаниям, по инициативе врача. Без рентгенологического исследования нельзя определить ни локализацию очагов, ни их число, ни их плотность и характер контуров, которые могут указывать на давность процесса и вариант течения очагового туберкулеза. Поэтому очаговый туберкулез легких в основном выявляется при профилактической флюорографии и значительно реже при диагностическом рентгенологическом исследовании.
Кроме рентгенологического метода, высоко достоверным признаком в диагностике очагового туберкулеза имеет обнаружение БК в мокроте или промывных водах бронхов (бактериоскопическое исследование выполняется не менее 3-х раз с 2-3 кратным посевами материала на питательной среде).
Однако в силу ограниченности туберкулезного процесса при очаговой форме и редким распадом легочной ткани бактериовыделение обнаруживается сравнительно не часто. Так, без распада в фазе инфильтрации МБТ обнаруживаются даже при тщательной бактериоскопии только у 1-3% больных, а при применении метода посева не более чем у 10-20% больных.
Обычно у больных очаговым туберкулезом бактериовыделение скудное, не представляет серьезной эпидемиологической опасности, но имеющее большое диагностическое значение для подтверждения диагноза туберкулеза.
Другие же лабораторные исследования при очаговом туберкулезе малоинформативны. Так, например, туберкулиновая чувствительность по пробе Манту в стандартном разведении с 2ТЕ ППД-Л характеризуется нормэргическим или гипоэргическим характером. Гиперергические пробы выпадают сравнительно редко, что в таком случае свидетельствует о туберкулезной природе выявляемых рентгенологически очагов и об их активности.
Гематологические показатели крови при общем и биохимических исследованиях или нормальные, или имеет небольшие отклонения в сторону повышения некоторых из них (СОЭ, количество лейкоцитов, изменение альбумино-глобулинового коэффициента, белковых фракций, СРБ, сиаловых кислоты, гаптоглобина и серомукоида).
Особое внимание надо обратить на диагностику активности фиброзноочаговых изменений в легких, которые выявляются, как правило, на разных этапах и фазах развития очагового процесса. Поэтому проблема диагностики очагового туберкулеза легких и особенно определение его активности является и остается одной из важных и трудных проблем современной фтизиатрии.
Среди признаков активности следует выделить достоверные и косвенные.
1. Достоверные:
1) обнаружение бактериовыделения;
2) положительная или отрицательная динамика туберкулезных изменений в легких, доказанная повторными рентгенологическими исследованиями в процессе наблюдения.
Однако в начале наблюдения эти признаки в большинстве случаев отсутствуют и могут быть выявлены только через несколько месяцев.
В связи с этим особое значение для своевременного определения активности очагового туберкулеза легких в сомнительных случаях приобретают косвенные признаки.
2. Косвенными признаками являются:
1) выявление невыраженных симптомов туберкулезной интоксикации;
2) локальные признаки активности воспалительного процесса в легких, определяемые физикально и рентгенологически;
3) признаки активности туберкулеза, полученные при диагностической бронхоскопии;
4) появление не только местной, но и общей реакции организма на подкожное введение туберкулина в дозе 50 или 100 ТЕ (по типу пробы Коха).
При отсутствии явных достоверных и косвенных признаков активности в некоторых случаях вопрос решается при динамическом наблюдении за состоянием больного, т.е. используется, так называемый, диагностический тест-времени. При обнаружении даже незначительных признаков предполагаемой туберкулезной интоксикации или многочисленных очаговых теней особенно в обоих легких, применяется тест-пробной химиотерапии тремя противотуберкулезными препаратами до 2-х месяцев в дневном стационаре или санатории. При отсутствии динамики через 2 месяца лечения процесс в легких рассматривается как неактивный.
Прогноз и исходы. При правильном лечении больного очаговым туберкулезом легких и переносимости препаратов прогноз для жизни, здоровья и трудоспособности, как правило, благоприятный. Смертельных исходов от очаговой формы туберкулеза не бывает, если очаговый процесс при стечении ряда неблагоприятных факторов и прогрессировании не переходит в другие более распространенные формы, которые и определяют последующий прогноз у больного. Подобное положение отмечается не более чем у 2-7% больных.
Полное рассасывание туберкулезных очагов в легких также наблюдается редко (у 3-5% больных).
У большинства же, или у 90-95%, больных при наступлении клинического излечения, как правило, формируются в легких остаточные неактивные фиброзноочаговые изменения. Часть очагов может подвергнуться кальцинации. Такие очаги называются кальцинатами или петрификатами.
Не нашли то, что искали? Воспользуйтесь поиском:

Что такое микобактерия туберкулёза

Именно Роберт Кох предложил алгоритм для идентификации вызывающих туберкулёз бацилл, получивший также его имя (триада Коха) и применяемый до сих пор. Суть алгоритма состоит в следующем:
- Из тканей больного пациента извлекаются бактерии.
- Из них выращивается чистая культура – колонии бактерий.
- Далее, для получения клинической картины болезни, происходит заражение здорового организма (лабораторные мыши).

Клетка МБТ состоит из:
- микрокапсулы, защищающей микобактерию от внешних воздействий и связанной с клеточной стенкой;
- клеточной стенки, которая обеспечивает клетке стабильность её формы и размера;
- гомогенной цитоплазмы и цитоплазматической мембраны;
- ядерной субстанции (собственно набор хромосом и плазмиды).

За свою тысячелетнюю историю бактерии приобрели различные механизмы защиты и приспособления к неблагоприятным для них внешним условиям.
Оптимальная для роста МБТ температура – 37 – 38°С. Размножаются они при температурном режиме от 29°С до 42°С. Однако, туберкулёзные палочки в состоянии сохранить свою жизнеспособность в условиях как очень низких, так и довольно высоких температур (н.п., при температуре в 80°С палочка является жизнеспособной ещё на протяжении 5 минут, при кипячении гибнет через 15 минут).
Наиболее комфортно бактерии чувствуют себя в сырых и тёмных условиях, на ярком солнце и при высокой температуре окружающей среды они прекращают интенсивное размножение и гибнут через полтора-два часа. Ультрафиолетовые лучи в состоянии уничтожить микобактерии за 2 – 3 минуты.
На протяжении многих месяцев МТБ в состоянии выжить, находясь вне живого организма. В водной среде они сохраняются около 150 дней, в пыли на улицах – до 10 дней, на книжных страницах до 3 месяцев. В высушенной форме микобактерии могут выживать в периоде до 3-х лет, а в замороженном состоянии их жизнеспособность может достигать и 30 лет.
В неблагоприятных для бактерии условиях, при лечении туберкулёза с помощью химиотерапии или при мощном иммунитете, палочка Коха быстро вырабатывает устойчивость к препаратам, может принять L -форму, способна сохраняться в таком состоянии целые десятилетия и вызывать противотуберкулёзный иммунитет. У пациентов, длительное время принимавших противотуберкулёзные препараты, бактерии могут принимать мелкие фильтрующиеся формы.

Практически любой орган или ткань человеческого организма, включая костные ткани, может быть подвержен заболеванию туберкулёзом. Более 90% всех случаев заболевания поражает органы дыхания. Наиболее часто из других внелегочных форм происходит поражение микобактериями мочеполовой системы, суставов, печени и почек.
Лабораторная диагностика и методы исследования материала на содержание микобактерий

При подозрении на туберкулёз внелегочных форм в качестве материала для лабораторного анализа также используют кусочки тканей органов, взятые при биопсии, пункциях и соскобах.
Если речь идёт о возможном заражении половой или мочевыделительной системы, на анализ берут мочу, собранную после ночного сна утром, как правило, это средняя порция мочи. У женщин для обследования на туберкулёз женских половых органов используют менструальную кровь, которую собирают с помощью колпачка Кафки.
В исследовании материала современная медицина применяет следующие методы:
- бактериологические;
- микроскопические;
- аллергологические;
- биологические;
- молекулярно – генетические и серологические методы (применяются достаточно редко).

Для обнаружения L -форм используется в большинстве случаев фазово-контрастная микроскопия.
Необходимо просмотреть не менее 100 полей зрения для вынесения положительного ответа при обнаружении mycobacterium tuberculosis , при этом следует указать число бактерий в каждом поле. Однако следует отметить, что наличие отрицательного результата при микроскопии не даёт гарантии полностью исключить диагноз туберкулёза.
Микроскопический метод анализа имеет определённые недостатки, к которым в первую очередь относится низкая чувствительность: mycobacterium tuberculosis обнаруживается только при присутствии не менее 50 – 100 тысяч микробов на 1 мл исследуемого материала. Этот метод не позволяет отличить mycobacterium tuberculosis от других видов mycobacterium , он также не в состоянии определить чувствительность микобактерий к определённым химиотерапевтическим препаратам.
Главный недостаток этого метода состоит в том, что получение конечных результатов требует определённых затрат времени (от 3 до 12 недель). На искусственных средах рост микобактерий наступает через 3 – 6 недель. У пациентов, проходящих курс химиотерапии, выделенные штаммы вырастают на ещё более поздних сроках (от 50 до 80 дней). На сегодня современной медициной испытаны и ускоренные методы выращивания культур mycobacterium tuberculosis по методу Прайса (на препаратах – мазках) и по методу посева на кровяной среде.
С помощью бактериологического метода можно определить не только вирулентность культуры, но и её чувствительность к различным медицинским препаратам.

При этом методе материал вводиться морским свинкам подкожно или в брюшную полость. Если в материале присутствуют вирулентные mycobacterium tuberculosis , то обычно через 10 – 12 дней на месте инъекции образуется уплотнение, которое переходит в незаживающую язву. На протяжении 2 – 4 месяцев развивается генерализованный туберкулёз и свинки погибают.
Ускоренный биологический метод заключается во введении материала в региональный лимфоузел морской свинки. Увеличенный узел вырезается на 8 – 10 день и исследуется на присутствие микобактерий туберкулёза в препаратах-отпечатках.
В связи, с распространением в последние годы изменённых и устойчивых микобактерий чувствительность этого метода заметно снизилась. На сегодняшний день метод применяется в крупных специализированных лабораториях и требует строгого соблюдения режима проведения.

При помощи пробы Манту определяется круг лиц для проведения ревакцинации. Положительная проба Манту не является обязательным признаком наличия заболевания.
Профилактика

Взрослым с целью выявления туберкулёза на ранних стадиях не реже 1 раза в год необходимо проходить флюорографию лёгких в поликлинике. При резких изменениях реакции Манту за год или в случаях контакта с инфицированным больным фтизиатр может предложить проведение курса профилактической химиотерапии.
Читайте также:









